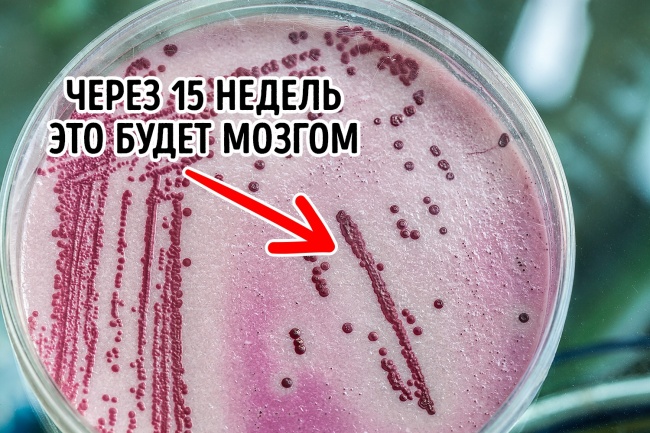

Науковці зробили 12 відкриттів, з-за яких нам стало якось не по собі

З кожним днем наука рухається вперед. Розширюючи межі людських можливостей, вона, мабуть, розігналася до такої швидкості, що готова подарувати нам філігранно скопійовані кадри самого сміливого фантастичного фільму.
Ми в Social.org.ua вирішили розібратися, чи всі відкриття направлені на благо людства і не варто чекати «підніжки» від науки майбутнього.
Трансплантація людської голови
Італійський нейрохірург Серджо Канаверо готовий взяти на себе одну з функцій бога — воскрешати людей. Вчений запевняє, що трансплантація людської голови цілком реальна, і найближча операція призначена на 2018 рік. Професор вже подарував нові тіла щурам, собаці і мавп, але як мозок відреагував на це — не повідомляється. Якщо експеримент Серджо увінчається успіхом, то це не стільки підірве світ науки, скільки налякає громадськість і нагадає про сюжеті культового «Франкенштейна» Мері Шеллі.
Штучна амнезія
Хотіли б ви назавжди позбутися фобій, тривог, неприємних спогадів або ж страхів? Вчені готові выскрести з вашої пам'яті всі темні моменти, не торкнувшись при цьому потрібні ділянки вашої історії, з допомогою комбінації технологій сканування мозку і штучного інтелекту. Так, безсумнівно, відмінна новина, але якщо на секунду задуматися про те, що цим лайфхаком скористаються для маніпуляції мозком... Тепер ідея так собі, правда?
Вода на Марсі
У 2016 році НАСА повідомило радісну новину: на Марсі є крихітні крижані озера. Вчені не виключають той факт, що вода може текти і під марсіанської грунтом, а де є вода, є і життя. Відкриття наштовхує на думки про позаземної цивілізації. Крім цього, потрібно запитати себе: що буде, коли Марс розігріється і вода почне підтримувати життя?
Діти від трьох батьків
У 2016 році на світ з'явився малюк з генами від трьох батьків. Науковий переворот дозволив сімейній парі народити абсолютно здорову дитину, незважаючи на те що жінка страждала від смертельного захворювання. Але це далеко не перший трехгенный експеримент — той, що пройшов у 1990-х роках, дав збій, і «ексклюзивні» діти успадкували генетичні порушення.
Органи, вирощені в пробірці
Учені Австрійської академії наук витратили 15 тижнів, щоб виростити в чашці Петрі найважливіший орган людини — мозок. Лабораторний продукт мав той же рівень розвитку, що і у 9-тижневого плоду. На щастя або на жаль, мозок мислити не може, але це всього лише питання часу, так як експерименти тривають. В такому випадку виникає питання: наскільки якісно буде функціонувати орган і не «злетить» чи вона в майбутньому?
Хвороби від пластику
Пластик став наркотиком XXI століття. Ми зустрічаємо його на кожному кроці і не замислюємося про негативні наслідки, а дарма, адже отруйні хімікати ми проковтуємо практично кожен день. Рак матки, молочної залози, серцевий напад і діабет — калейдоскоп «сюрпризів» на цьому не закінчується. Якщо що, ми вас попередили.
Нанороботи всередині людини
Нанороботи розміром з молекулу стали черговим хітом в науковому світі в 2015 році. Ці малятка здатні зберігати і доставляти ліки до уражених ділянок тіла, а також знаходити хворі клітини. Відмінне відкриття, згодні? Але що, якщо мікророботи потраплять в руки нехороших людей?
Над нами 1 млрд планет, схожих на Землю
Два роки тому хлопці з НАСА прийшли до висновку, що тільки в нашій галактиці можуть обертатися близько 1 млрд сестричок Землі — планети, де людина могла б продовжити свій рід. Цей факт тільки підживлює думки про те, що в цьому Всесвіті ми не самотні.
ЗD-друк людської шкіри
Якщо ви до цих пір в шоці від надруковані на 3D-принтері будинків, то ми поділлям масла у вогонь: вчені представили биопринтер, який друкує повністю функціонуючу шкіру людини. Шкіра придатна для пересадки або медичних експериментів. А тепер уявіть, як людини одягають у псевдонатуральную шкіру. Викликає мурашки і побоювання.
Мікроби еволюціонують швидше, ніж ми знаходимо ліки від них
Незважаючи на те, що медицина біжить вперед все швидше і дарує нам антибіотики і вакцини від багатьох недуг, деякі бактерії обганяють її на пару кроків. Вірус грипу, наприклад, мутує з такою швидкістю, що торішня вакцина вже неефективна. Навіть в просунутому XXI столітті є немаленька можливість померти від туберкульозу.
Загадкова Всесвіт
Наша Всесвіт настільки неосяжна і загадкова, що всі наші знання про неї поміщаються всього в 4 %. Темна матерія і темна енергія — основні її «органи» — зовсім не вивчені. Єдине, у чому впевнені астрономи: Всесвіт росте завдяки її темним частинах. Вона буде розширюватися до того моменту, поки не стане холодною і спустошеною. Це і зачаровує і лякає.
Пульт дистанційного керування мисленням
Маленький кумедний факт зі світу науки вже покрився сивиною — в 1923 році дослідники навчилися контролювати нейрони в мозку і викликати мимовільне рух кінцівок і маніпулювати почуттями. Розлючений бик став першою жертвою експерименту — сердите тварина заспокоювали за секунду легким натисканням на спеціальні кнопки пульта. До тестів над людьми вчені не дійшли, але думки про прихований потенціал контролю мозку бентежать.
Фото на превью depositphotos